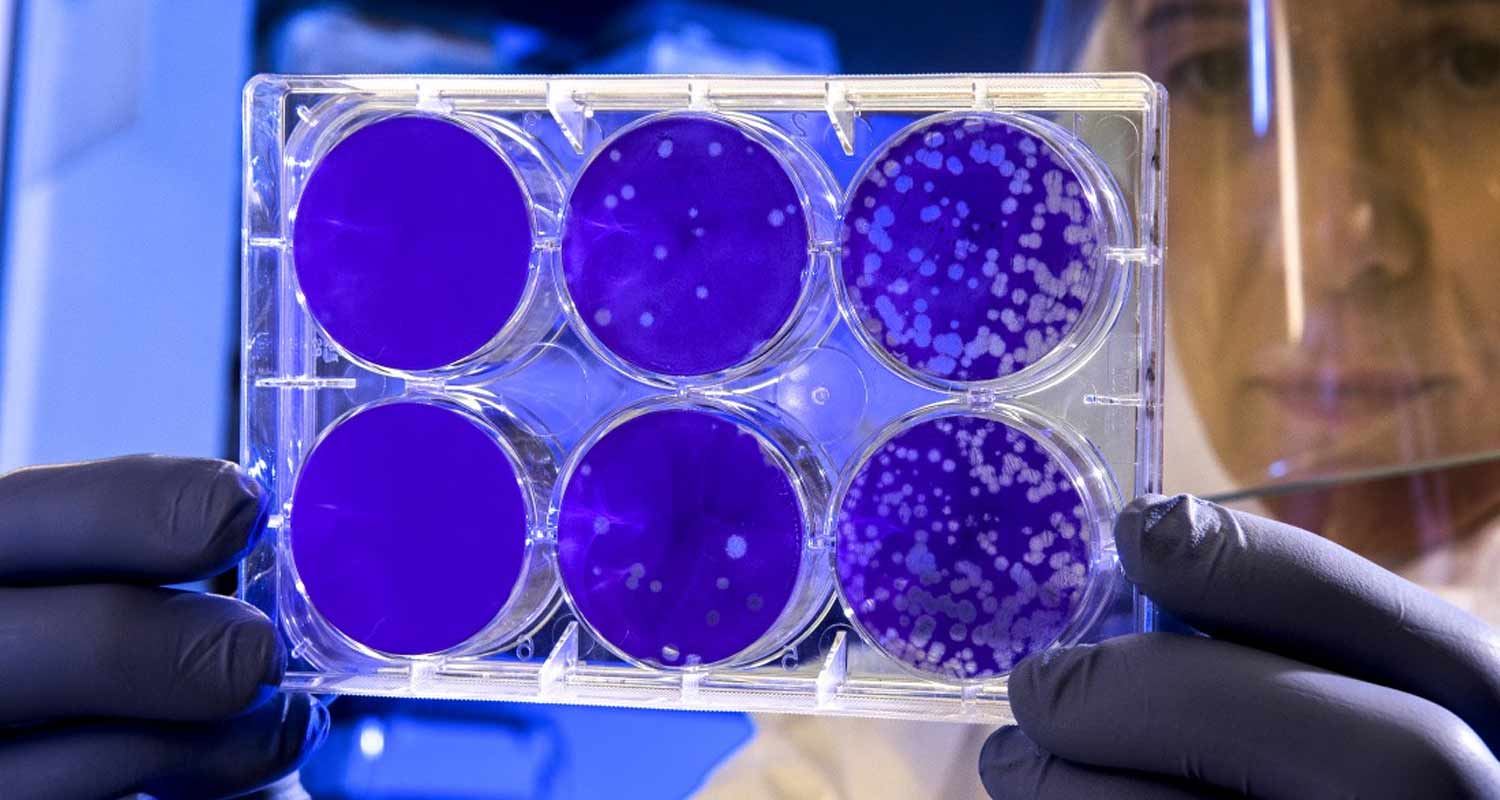
Monkeypox, il vaiolo delle scimmie non sarà una pandemia

Monkeypox, il vaiolo delle scimmie non sarà una pandemia
di Redazione
02/06/2022

L'OMS sta valutando se l'epidemia debba essere analizzata come una "potenziale emergenza sanitaria pubblica di interesse internazionale", ma non è "preoccupata" per una pandemia.

L'Organizzazione Mondiale della Sanità (OMS) ha ritenuto questo lunedì improbabile che un focolaio del virus Monkeypox (vaiolo delle scimmie) al di fuori dell'Africa possa portare a una pandemia.
In un briefing, citato dall'agenzia di stampa Reuters, sulla diffusione del virus, Rosamund Lewis, specialista del vaiolo con il programma emergenze dell'OMS, ha affermato che non è stato ancora confermato se le persone infette ma asintomatiche possano trasmettere il virus.
"In realtà, non sappiamo ancora se vi sia una trasmissione asintomatica di Monkeypox - in passato ci sono state indicazioni che questo non è un tratto importante - ma questo deve ancora essere determinato", ha spiegato.
Lewis ha aggiunto che l'OMS sta valutando se l'epidemia debba essere analizzata come una "potenziale emergenza sanitaria pubblica di interesse internazionale" , simile a quanto fatto per Covid-19 ed Ebola, al fine di accelerare le indagini e i finanziamenti per contenere il diffusione della malattia.
Alla domanda se l'epidemia di vaiolo delle scimmie potrebbe trasformarsi in una pandemia, Lewis ha detto: “Non lo sappiamo, ma non lo pensiamo. In questo momento, non siamo preoccupati per una pandemia globale".
Secondo il Centro europeo per la prevenzione e il controllo delle malattie (ECDC), al 25 maggio si sono verificati 118 casi di infezione da virus Monkeypox in 12 Stati membri dell'Unione Europea (UE).
Il virus Monkeypox fu scoperto per la prima volta nel 1958 quando si verificarono due focolai di una malattia simile al vaiolo in colonie di scimmie tenute per la ricerca.
Il primo caso umano di infezione da virus Monkeypox (vaiolo delle scimmie) è stato registrato nel 1970 nella Repubblica Democratica del Congo, durante un periodo di raddoppiati sforzi per eradicare il vaiolo. Da allora, diversi paesi dell'Africa centrale e occidentale hanno segnalato casi.
Sebbene la malattia non richieda una terapia specifica, il vaccino contro il vaiolo, gli antivirali e l'immunoglobulina vaccinica (VIG) possono essere utilizzati come prevenzione e trattamento per tale virus.
Articolo Precedente
Cruise: L'auto del futuro arriva a San Francisco
Articolo Successivo
Tutte le caratteristiche del nuovo Xiaomi Pad 6



